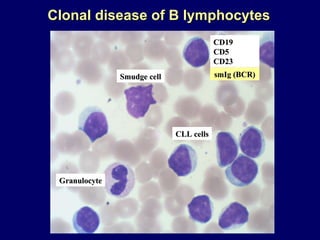
Smudge cell Granulocyte CLL cells CD19 CD5 CD23 Clonal disease of B lymphocytes smIg (BCR)

This document summarizes research on the immunobiology of chronic lymphocytic leukemia (CLL). Key points include:
1. CLL results from the selection and transformation of B cells expressing B-cell receptors (BCRs) of restricted structure that can be polyreactive and autoreactive.
2. These BCRs bind to natural antigens as well as novel autoantigens generated during apoptosis.
3. CLL subgroups differ in retention of polyreactivity, with retention associated with worse clinical outcomes. Binding to autoantigens on apoptotic cells correlates with poor survival.

![~20% of mAbs from CD5 + B cells from normal subjects ~75% of mAbs from CLL cells ~90% from unmutated CLL ~60% from mutated CLL Reactivity of recombinant mAbs with viable HEp-2 cells that were permeabilized to allow Ab entry [“Anti-cell antibodies”] Reactivity mainly with cytoplasmic structures and occasionally with nucleoli. Only one mAb from M-CLL patient reacted with nucleus in a homogeneous pattern Herve et al . J Clin Invest 115:1636-1643, 2005](https://image.slidesharecdn.com/01-2chiorazzipcaeccretreat5-5-10forwebsite-100607102627-phpapp02/85/Session-1-2-Chiorazzi-26-320.jpg)





















